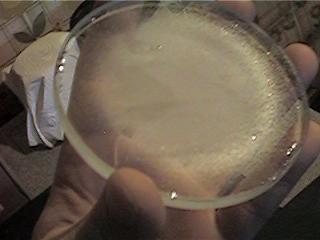

Das 12Zoll Selbstschliff(Lulatsch) Projekt Teil 1- Der Sucher
Der Bericht sollte zusammen mit diesem Tagebuch gelesen werden.

Hier kann man mal sehen , wie klein das Ding ist. Zum Vergleich liegt eine Zigarettenschachtel neben dran.
Nach 4 Chargen K-80 ist die Scheibe gerade mal angekratzt.


Nach weitere 6 anstrengenden Chargen K-80 sah es dann so aus. Rechts bei der Messung mit dem Sphärometer. Ich glaube die Brennweite war damals gerade mal 1,20m.

Hier bin ich dann endlich nach 6 Tagen zum Feinschliff mit K-180 über gegangen.

Das Beschicken der Schleifschale mit K-180.


Der 'Bleistift' Test auf Sphäre mit einem Edding. Verschwinden alle Striche gleichmässig wie rechts ist die Sphäre erreicht.

Der Feinschliff ist beendet und es darf Poliert werden. Bis jetzt sind ca. 2 Monate vergangen.


Das Vorbereiten des Spiegels und der Schleifschale zum Pechhaut giesen.


Die fertige Pechhaut ist links. Rechts kann man sehen das nach mehrmaligen Warmpressen alles sitzt und angepasst ist.

Nach 40 min Politur

Nach 2 Stunden Politur

Nach 6 Stunden Politur. Die Brennweite ist genau 448mm also ein f/4.5(Mit Foucault gemessen).

Der Spiegel ist auspoliert und kann Parabolisiert werden. Das war ein Mist, ich war da wohl etwas zu heftig. Die erste Strehlmessung nach dem Parabolisieren zeigte eine gewaltige Hyperbel. Das Ding war um das 2,7 fache überkorrigiert. Nun versuchte ich die Parabel wieder zurück zu holen. Das ganze natürlich mit einem fullsize Tool. Das bringt Freude ! Dabei hat natürlich der Rand gelitten. Ich schnitt mit einen Papierstern von der Größe des Lochs (3-4cm) und legte es auf die warme Pechhaut. Das pressen vertiefte die Mitte nun so, das hier nichts mehr passieren konnte. Nun brachte ich den Spiegel wieder auf 1,8 fache Überkorrektur runter. Aber wer kann schon mit 0,20 Strehl leben ? Wieder war es die Zone 2 bei 70% , die mir zu schaffen machte. Dieses mal versuchte ich die Zone mit dem Daumen in den Griff zu bekommen. Das klappt auch einigermaßen gut. Mit Drehbewegungen des Spiegels versuchte ich das ganze so gleichmäßig wie möglich hin zu bekommen.

Nach fast weiteren 5 Stunden war ich dann bei 0,78 Strehl angekommen. Dieses Ergebnis erzielte ich durch 3 Messungen und drehen des Spiegels um 45 Grad. Wenn ich in nur einer Stellung messe, komme ich auf über 0,80 Strehl. Das sollte für einen Sucher reichen.

Den OAZ habe ich mir komplett selbst gedreht. Ist mein erster Drehfokusierer. Die Spinne ist aus 0.5mm Alu und auch komplett selbst gebaut. Den Offset habe ich bei dem 35mm Fangspiegel(sowie so zu groß) außer Acht gelassen.

Der Spiegel liegt auf 3 Silikon-Plobs. Die Stäbe sind aus Alu.

Er ist von unten über drei Muttern(mit Federn) justierbar.

Sieht doch Schmuck aus , oder ? Das ganze wiegt komplett mit dem 25er Okular nur 1.2 Kg. Die Daten: Länge komplett:440mm
Durchmesser :160mm
Brennweite :448mm
Spiegeldurchm.:100mm
Öffnungsverh. :f/4,5
Gewicht :1,2 Kg (komplett mit Oku und allem)
geplantes Oku.:25mm , sollten ca. 2.7 Grad Gesichtsfeld bei 18X sein
Ein erster Sterntest zeigt die immer noch vorhandene Überkorrektur von ca. 0,2 Lambda und den abgesunkenen Rand. Aber immer hin 60X am Mond sehen Klasse aus. Ich denke ich lasse das erst mal so. Nun geht es mit der Mutter von dem Kind weiter, die Ihn auf dem Rücken trägt. Das ganze wird in der Zeit wo beide Spiegel bei Befort sind mit Bootslack überzogen. Für alle die es interressiert habe ich hier mein myNewton File zum Download Nachtrag:

Ich mußte an den Sucher vor dem Belegen nochmal dran um die Überkorrektur weg zu bekommen. Ich konnte die 0.78 Strehl nicht auf mir sitzen lassen :-). Also ich denke so kann ich ihn belegen. Das ist nun wirklich ein "Finder".

Den Spiegel habe ich selbst Chemisch Versilbert. Erstens war für mich der Kostenpunkt ausschlaggebend, dann alles selbst gemacht zu haben. Mann findet zahlreiche Anleitungen im Internet. Bitte beachtet aber alle Sicherheitsvorkehrungen ! Das Zeug ist Super ätzend und Gefährlich !!!! Wenn man aber alle Richtlinien einhält, kann nicht passieren. Die Kosten für die Silberbelegung waren ca. 8 Euro (anteilig). Der Nachteil: Die Schicht ist etwas anfälliger und muß nach ein paar Monaten(oder Jahre) aufpoliert werden.

Als Okular setze ich das Vixen 36 Super Plössl ein. Es bringt an dem Sucher 12x Vergrößerung und ein Gesichtsfeld von 4 Grad. So sieht er nun aus. M13 war damit super zu finden, und schön hell. Wie Ihr sicher bemerkt habt, ist er schon an dem 12 Zoll dran montiert. Der 12er liegt in den letzten Stunden seiner Fertigung. Erster Test mit dem unbelegten Spiegel war sehr beeindruckend. Stefan , ein Freund ,war von der Schärfe am Jupiter begeistert. Die Seite mit dem 12er folgt in Kürze. Auf einem Frame gelandet ? Hier geht zur Hauptseite